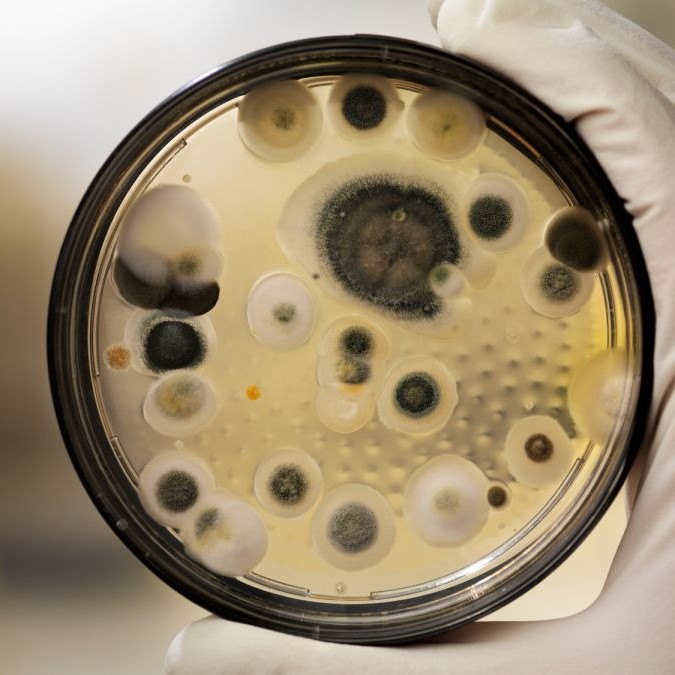
black mold test kit

Understanding the Dangers of Black Mold
Black mold is a term that strikes fear into the hearts of homeowners. It is scientifically known as Stachybotrys chartarum. This type of fungus thrives in damp, humid environments. It often grows on materials with high cellulose content. Examples include drywall, carpet, and ceiling tiles. The primary danger lies in the production of mycotoxins. These are toxic substances that can become airborne. When inhaled or ingested, they cause various health problems. Common symptoms include chronic coughing, sneezing, and eye irritation. In some cases, it can lead to neurological issues. Therefore, identifying its presence is crucial for maintaining good health. Many people live with mold without realizing it. The growth often hides behind walls or under floorboards. If you suspect an issue, immediate action is required. You cannot rely solely on visual inspections. A specialized black mold test kit provides the certainty needed for remediation.

Consequently, the health of the occupants deteriorates slowly. Doctors often treat the symptoms without finding the root cause. This leads to prolonged suffering and unnecessary medical bills. Furthermore, mold can cause structural damage to a home. It feeds on organic materials. Over time, this weakens the integrity of the building. Floors may start to sag. Walls might become soft. The cost of repairs escalates the longer the problem persists. Ignoring the issue is never a good strategy. Early detection is the key to preventing extensive damage. Homeowners must remain vigilant. They should inspect areas prone to moisture regularly. Bathrooms, kitchens, and basements are common hotspots.
Why You Need a Black Mold Test Kit
Many homeowners question the necessity of purchasing a testing kit. They might believe that visible mold is enough to confirm a problem. However, visible mold is often just the tip of the iceberg. Most fungal growth remains hidden from plain sight. It might even grow underneath your flooring. Relying solely on your eyes is a risky gamble. A black mold test kit offers scientific proof. It removes the guesswork from the equation. You gain definitive answers regarding the air quality in your home. This is especially important if you have young children or elderly relatives. Their immune systems are more vulnerable to the effects of mycotoxins.
Additionally, using a test kit is often more cost-effective than hiring a professional initially. Professional inspections can cost hundreds of dollars. A DIY kit allows you to screen your home at a fraction of the price. It puts the power of monitoring in your hands. You can test different rooms individually. This helps to pinpoint the exact source of the contamination. Furthermore, knowing the type of mold is essential for proper removal. Not all molds are toxic. However, you need to know which type you are dealing with.
Some kits provide specific identification. This information is vital for planning the cleanup process. For instance, small patches of non-toxic mold might be cleanable with household products. Conversely, a large infestation of toxic mold requires professional remediation. The test results dictate the appropriate response. Thus, a small investment in a test kit can save thousands in unnecessary cleaning costs. It ensures you tackle the problem correctly the first time.

Exploring Different Types of Testing Kits
The market offers a variety of options for homeowners wanting to test for mold. Understanding the differences between them is important. Each type of kit has its own set of advantages. The most common type is the petri dish or “settle plate” method. This kit requires you to expose a nutrient-filled dish to the air for a set period. You then seal it and wait for growth. This is an affordable and simple way to detect airborne spores. However, it does not always provide precise counts. It simply tells you if spores are present. Another popular option is the instant check swab test. This involves swabbing a visible surface. You then apply a reagent. A color change indicates the presence of mold. This method is quick. It yields results in minutes. But it does not usually tell you the specific species of mold.
For more detailed information, many people choose a tape lift kit. This involves pressing a clear adhesive tape onto a surface. You then send this sample to a laboratory. Lab analysis provides the most accurate results. It identifies the specific types of mold spores. It also quantifies the concentration. This data is extremely helpful for understanding the severity of the infestation. Some advanced kits use air sampling pumps. These devices pull a specific volume of air through a collection cassette.
This method is highly accurate for measuring air quality. It mimics the techniques used by professional inspectors. When selecting a black mold test kit, consider your specific needs. Do you need a quick “yes or no” answer? Or do you need detailed data?
Step-by-Step Guide to Using Your Kit
Using a testing kit correctly is vital for accurate results. Most kits come with detailed instructions. However, the general process follows a standard procedure. First, you must prepare the testing area. Close all windows and doors in the room you wish to test. This prevents cross-contamination from outside air. It also allows the spores to settle. Turn off any fans or air conditioning units. Airflow can disrupt the settling process. Wait for the recommended time. This is usually around an hour. During this time, minimize movement in the room. You do not want to stir up dust. Locate a flat surface, such as a table. Place the testing medium there. If you are using a petri dish kit, remove the lid. Leave it exposed for the time specified in the instructions. This is typically between 30 to 60 minutes.
After the exposure time has passed, seal the dish immediately. Then, store it in a safe place away from sunlight. You will need to wait for the incubation period. This can take several days. Most kits require you to check the dish daily. Look for any signs of growth. Fuzzy spots of various colors usually indicate mold. If you are using a swab test, the process differs slightly. Put on the provided gloves. Gently rub the swab over the suspicious area. Apply the testing solution as directed. Observe the reaction.

If you are using a tape lift or air cassette, you must prepare the sample for mailing. Carefully seal the sample in the provided container. Fill out the chain of custody form. This document is important for lab processing.
Interpreting the Results Accurately
Receiving the results from your test can be confusing at first. You might see a list of scientific names and numbers. It is important to understand what these figures mean. For petri dish tests, the visual result is often binary. You either see growth, or you do not. If you see black or dark green colonies, you likely have a problem. However, not all black molds are toxic. Many harmless molds are also black in color. Therefore, you cannot rely solely on the color. You must consider the quantity. A few small spots might be normal. However, a dish covered in growth indicates a serious issue. For lab-based results, the report will list the types of spores found. Common indoor molds include Cladosporium, Penicillium, and Aspergillus. Stachybotrys chartarum is the toxic black mold you are looking for.
The report will also show the concentration of spores. This is usually measured in spores per cubic meter of air. Comparing these numbers to outdoor levels is a standard practice. In a healthy home, indoor spore levels should be lower than outdoor levels. If your indoor levels are significantly higher, it confirms an indoor source of contamination. The presence of Stachybotrys is a red flag, regardless of the count. This mold does not become airborne easily unless it is disturbed.
Therefore, finding it suggests an active and potentially large growth site nearby. If your results show high levels of toxic mold, you should take immediate action. Do not disturb the area. Disturbing it can release a massive amount of spores.
When to Call a Professional
DIY kits are excellent for initial screening. However, they have limitations. There are scenarios where calling a professional mold inspector is the best course of action. If the test results indicate a large infestation, you need expert help. Generally, if the mold covers an area larger than 10 square feet, the EPA recommends professional remediation. Attempting to clean a large area yourself can release dangerous toxins. Professionals have the equipment to contain the area. They use negative air machines to prevent spores from spreading. They also wear protective suits. This ensures their safety during the cleanup. Furthermore, if the mold is in your HVAC system, do not attempt to clean it yourself. The spores can spread to every room in the house. This would contaminate the entire living space.
Additionally, if you or a family member suffers from severe health issues, professional removal is safer. Disturbing the mold can cause a severe reaction. Professionals know how to handle hazardous materials safely. They also address the root cause of the moisture. Mold needs water to grow. Simply removing the mold is not enough. You must fix the leak or the humidity problem. If you cannot find the source of the moisture, a professional can help. They use moisture meters and thermal imaging cameras.
These tools detect hidden leaks behind walls. Sometimes, a black mold test kit reveals a problem that is too complex for a DIY solution. Recognizing the limits of your ability is important. Safety should always be the top priority. Professional remediation ensures that the mold is gone for good. It prevents it from returning in the future. Investing in professional services is an investment in your home’s structural integrity and your family’s health.
Preventing Future Mold Growth
Once you have addressed a mold issue, prevention becomes the focus. You do not want the fungus to return. The key to mold control is moisture control. Mold spores are everywhere. You cannot eliminate them entirely. However, you can deny them the water they need to grow. Start by controlling the humidity levels in your home. The ideal humidity is between 30% and 50%. Use a dehumidifier in damp areas like basements. Fix any leaks immediately. This includes leaky roofs, windows, and pipes. Even a small, persistent drip can lead to a major mold problem over time. Ensure your home has proper ventilation. Use exhaust fans in the bathroom when showering. Use them in the kitchen when cooking. This removes excess moisture from the air.
Furthermore, inspect your home regularly. Look under sinks and around toilets. Check the corners of showers. If you see condensation on windows, wipe it away. Condensation is a sign of high humidity. Improve the airflow in your home. Move furniture away from walls. This allows air to circulate freely. Do not store cardboard boxes directly on basement floors. They can absorb moisture and become food for mold. Instead, use plastic bins with tight lids. Regular cleaning also helps.

Long-Term Health and Safety Implications
Living in a mold-free environment has profound benefits for your long-term health. The respiratory system is particularly sensitive to mold spores. Continuous exposure can lead to chronic conditions. Asthma can develop or worsen. Allergies can become more severe. Children are especially at risk. Their lungs are still developing. Exposure to toxic black mold has been linked to developmental issues. It can also cause permanent lung damage. Therefore, using a black mold test kit is a proactive health measure. It is not just about home maintenance. It is about protecting the well-being of your loved ones. Mental health can also be affected. Living in a damp, moldy home causes stress and anxiety. The constant worry about health symptoms takes a toll. The smell of musty air is unpleasant. It can make a home feel uninviting.
Removing the mold improves the overall quality of life. Sleep often improves when air quality is better. Chronic headaches may disappear. Energy levels can return. The home becomes a sanctuary again. Furthermore, the financial implications are significant. A home with a history of mold issues is hard to sell. It decreases the property value. Buyers are wary of structural issues and health hazards. By maintaining a mold-free home, you protect your investment. You ensure the longevity of the building. Structural integrity remains sound. You avoid costly repairs down the road. Therefore, the small effort of testing is well worth it. It serves as an early warning system. It catches problems before they become disasters. Prioritize the air quality in your home. It is an invisible but essential component of a safe lifestyle. Take action today to ensure a healthier tomorrow.
